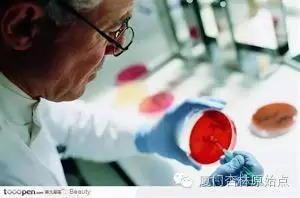
白血病大揭密

文章目录[隐藏]
血液化验后面的陷阱
朱浩文发热多次验血的故事背后一个只有2岁9个月的孩子,湖南人,叫朱浩文,发烧送医院,血液检查白细胞和血红蛋白基本无异常,只有血小板稍低。医生的治疗就是给孩子输液加消炎退烧药,其中放的是什么药我不知道,但总应该是医生认为是治病的药,至于它们会不会治好病我们要看结果。医生治病,既然要看血检单,用了药之后,是好是坏当然还是看血检单了。朱浩文的父亲,对这样的抽血化验产生了怀疑,于是,他把验血单记了下来做对比,我把这单子记录如下:

在家休息2天,竟然是白细胞自动恢复正常了;血红蛋白接近正常;血小板保持不动。这里说明,医院的验血和挂液治疗,不仅毫无效果,而且还有害处,即各项指标都在降低。人们当然要问:医院和医生对病人实施验血和输液,到底是干什么用的?我们不讲动机,只看结果,就知道它的目的了。说穿了,治疗的目的是为了使孩子得白血病。我们不应该责备医生,也不应该追究医院,而应该认真运用我们的中国式的哲学智慧,追究西方医学和医疗的来路和目的。7月6日,他再带孩子去去全国有名的中南大学湘雅医院检验,白细胞仍保持正常,但在湘雅输了2天液,7月28日在温州市中心医院检查,却发现白细胞和血红蛋白大幅度下降,而血小板上升到正常。

表格中白细胞4.4,而参考值11—12,可能是印刷出错。因为其他医院都没有这样的参考值。这样的血液检查,孩子做了7次,三个医院的3次治疗,每次数都是将孩子的血常规指标治得降低,因为,血指标低了就会被认为得白血病,难道这就是治疗的目的?我可以肯定,医生与医院都不会这么想的。他们做这工作只是在混饭吃。医疗的目的不是他们能掌握的。也就是说,他们只是把药卖出去这道程序中的工具。挂液退热消炎治疗后,热不退,于是再做血检,白细胞降低很快,医生说白血病可疑,要做骨穿。做了骨穿后,确诊为白血病。医生认为必须化疗。孩子的父亲却认为,化疗就必死无疑。如让孩子在忍受化疗的痛苦死去,不如在自己的怀抱里生病或安然地死亡。这里告诉我们的道理是:血液检查的后面,实际安着一个白血病的陷阱。
所以,认真对待医疗,如何正确选择,道理在于细心,我希望天下做父母的都要向朱浩文的父亲学习,不要一听医生的恐吓,就惊慌失措,把生命与健康的主导权都交给这个你毫不熟识、毫无相关的、毫无责任感的,而且用语言恐吓你的人。我曾经为此写下了:“用语言恐吓病人的医生,是最坏的医生。”“医疗,虽然能救人性命,但也能谋财害命。所以,有时候,医疗选择是一种生死选择。”当我们面临医疗选择的时候,大家一定要记住,宁可选糊里糊涂地活,千万不要选明明白白地死呀!一百年前,我国有位高级文化头头,他说,中医能治好病,但使人活得糊里糊涂;西医虽然不能治好病,却使人死得明明白白。因此,科学被迎来当做当做真理树立起来后,西方对内科病完全外行的医疗,也戴上科学的帽子跟着进来了。中国的当权者黑白未分,就把医疗管理的执掌权交给了它,称为卫生部。哪知道这卫生部的领导人马,几乎全是清一色的“中医杀手”。于是,他们就大刀阔斧地狠砍中医了。因此,中国人就没有办法糊里糊涂地活,而只能明明白白地死了。朱浩文的验血单中看出验血是个危险的骗局到医院治病,有一道检验工序叫验血,通过验血,可以分析出病人生的是什么病。可是,世界上的哲学家大概一听医疗两个字,思维就混乱了。否则,这种粗制滥造瞎扯蛋的检查方法是怎么通过科学鉴定的?但是,我们看朱浩文的验血单,不仅变化快,在家玩两天,血液的指标就变正常了,这个变化说明用血指标来确定生什么病,来决定治疗,就毫无意义。因为,医生看着血中某项指标数值降低,是按当时的数值决定给孩子做骨穿,抽骨髓。孩子就得住进医院并进行一系列检查,就是不会再检查血常规。因为他们都知道一检查,这假戏就马上会被揭穿,病人就不会再上血液科住院了。

湖南省儿童医院,根据孩子低烧、白细胞、血小板指标低,给孩子抽骨髓检查,诊断为急性淋巴细胞白血病,要浩文立即住院治疗。孩子的父亲表示不相信这种诊断,跟医师吵了一架,带孩子回家休息了2天,再到怀化市一医验血,发现白细胞恢复正常,血红蛋白接近正常,血小板保持不动。这不是表明两天前医生根据验血单判断得什么病毫无用处吗?然而,这种毫无用处的验血判病方法却在全世界所有的医院里实施,人们一点也没有发觉被骗。医生看着验血单上的血常规数字,只要低于或高于指标数的,都会要你抽骨髓。而病人与家属一点也不在乎。他们相信科学,相信医生的话。医生说骨髓一点也不会伤害病人。其实,骨髓是造血的“工厂”,你把造的“生产工人”抽掉了,还有不伤害的?当然,医生也有不知道的,但即使知道也没有办法,他需要医院的工作,以谋取一日三餐之资。医生要患者抽骨水检查,这是白血病可疑,需要做确诊的信号。但是,很少有几个人能逃脱“被白血病”的。因为,这个25%的数据是被西方制药公司豢养的医学家拟出来的。既然医生基本确认你得白血病了,他就会有方法使你接受白血病的帽子,然后你就是一个白血病人了。朱浩文的回家歇两天再检查,可谓贡献巨大,我们应该告诉全国的妈妈:你的孩子如果发烧经过用了药的,验血说他指标降低疑似白血病要抽骨髓检查的,千万要回家歇两天再做一次,这样就能减少白血病的发生率,让更多的宝宝过平安的日子。以做骨穿来证明是不是得白血病的做法和理论更不能相信。其一是幼稚白细胞这个概念,即尚未成熟的白细胞,相当于未成年人。一个国家能把所有的未成年人当敌人吗?简直是瞎扯!为什么这么说呢?这里有一个漏洞是:它规定幼稚白细胞达25%以上才能确诊为白血病。这说明25%以下是正常存在的。骨髓是人制造血液的工厂。在这个工厂里,存在半成品是极其正常的。因为,从半成品变成成品,需要的是一个时间过程。为什么要定一个25%的数字作为区分正常、不正常的标准呢?它告诉我们的信息是:所有人的骨髓,都存在一定的幼稚白细胞。为了利用它来制造病人,需要有一道分界线。以前,划分的标准是30%的。后来,贪婪的制药公司觉得这个指标制造出来的病人太少,就把指标降低,定为25%。前阶段,我接待一位白血病患者,他骨髓检查幼稚白细胞是24%,那医生说,这数字接近白血病危险了,可以打几次化疗来预防。那人说,幸好我已经看过你的书,知道这种欺骗了,就没有上当。今年2月份,网上有篇文章,是北京某大医院一个护士长写的揭露化疗杀死她堂妹的经过。她的堂妹是个跆拳道的拳手,身体非常结实。因检查身体验血,说她得了白血病,因自己的堂姐在这个出名的大医院当护士,有自己人好照顾,就选定进入这大医院治疗。但是却给治死了。人的生死是十分正常的。但未到天年就灭亡叫夭折,尤其是用药或手术使其夭折是很痛苦的。这文章写出了她堂妹痛苦死亡的原因,也暴露了这种集体医
疗体制的内幕。此文在网上发表不到五分钟就被删除,既说明西方制药公司的黑手势力之大无处不在。——本文转载自中医潘德孚

白血病初发,都有“类似感冒症状”,其实根本就是感冒。受寒发烧了,却治以寒凉冰冷的输液,身体感知到有“寒气”入侵,就自行以发烧来抵抗、排寒。发烧是能量的释放,在物质层面就表现为白细胞的运动【从骨髓跑到血液】,血液中白细胞增加。输入的冰冷液体越多,寒气越重,需要驱邪的白细胞就越多【淋巴细胞增多表现为淋巴结肿大】,多到一定程度就成了“白血病”。唯物论的客观论的西医是不会认识更谈不上承认无形可见的寒气【也叫低温】这个病因,也不会在乎患者主观的个人感觉【精神不振甚至萎靡、肌肉无力,发烧的同时手脚冰冷】。所以,“白细胞增多”这个结果现象,反而变成了病因,至于白细胞为何增多就“原因不明”。于是,降低白细胞就成了治疗的目标,手段是杀戮——于是,我军部队变成了敌军被消灭。于是,即使患者手脚已经冰冷,仍然不会停止输入冰冷的液体。
能量的表现形式是温度热能。持续冰冷液体的输入必然导致能量低下。同时,身体不断发烧,不断制造更多攻邪细胞会消耗大量的能量。能量是有限的,战争时期所有资源一律供应战斗部队所需,最惨的是提供粮草的平民老百姓。红细胞就是提供粮草的老百姓。能量都被战斗部队优先消耗了,红细胞自然生成不足。就表现为“贫血”。血小板也是建设部队,起止血作用,缺粮也多,生成减少,血止不住,则“出血”。青壮年都被杀戮了,最后出来的就都是些小年轻了,所以,“血象发现幼稚细胞”。脾生血,肝藏血,同时,肝是将军之官,对外抗敌的最主要器官,如此屡经大战,就像运动过后的肢体都会膨胀一样,就出现了“肝脾肿大”,厥阴肝经巡行部位包含胸椎骨区域,将军有病就会出现“胸骨压痛”。在中医,肝胆同属一个系统【肝胆相照】,在经络为厥阴少阳,所巡行部位【耳后、颈侧、腋下、腹股沟】就是淋巴结最集中的部位。所以,攻邪时这些部位都会出现“淋巴结肿大”。肝属木,肾属水,水生木,所以,肝肾是关系密切的两个系统,中医用“母子”来形容。

能制造白细胞,还算是有能量,输液“治疗”持续,杀戮继续进行下去,连造白细胞的能量都没有了,白细胞数量降下来了,“病好了”,但是很不幸,你又有另一个病了:再生障碍性贫血。以“全血细胞减少,骨髓造血功能低下”为内涵。别出院了,继续治病吧!
和血液有关系的病,检查项目中有一个脊髓穿刺抽检。知道往哪里抽吗?腰椎下面的缺口——命门穴。生命之门。里面高温高压,是督脉【包含人体最精华的能量】向上输送的管道,富于营养能量和动力。血液的生成靠的就是高温蒸化推动营养向细胞的转化。这一针插下去,压力顿减,还抽一管最富于营养的骨髓,什么叫抽筋抜髓?这就是!这是最严重伤害身体的行为。会造成造血功能的更严重损害。
动手术进行腰椎麻醉,也是在命门。麻醉的意思就是阻断阳气的传导,这个比抽髓还厉害!抽髓只是去掉一部分物质,麻醉剂注射进去影响的是整调脊髓包括脑髓。直接伤害大脑。所以腰麻后,整个智力水平都会明显下降。不少人感叹腰麻后记忆力大不如前。其实何止于此。生孩子为了避免疼痛选择麻醉,就连孩子也一并受罪。
造血靠的是什么?能量【热气阳气】作用于营养,以及压力【由热气形成】的输送。最核心的就是温度热能。只要热能充足,造血功能立即就可以恢复。造血功能不足,不是骨髓的问题,而只是热能不足的问题,病因是寒冷的病气输入太多。就像风扇不转,不是风扇本身有问题,而仅仅是没电没能量而已。何须换骨髓?
白血病如何治疗?很简单,就像治疗感冒一样:停止寒凉的继续入侵,加热,促使发烧,以流汗的形式把寒气烧出来,烧退,白细胞立即下降。热能一充足,骨髓立即开始造血。所有问题迎刃而解。因为,所有问题的本质,就是能量不足导致的功能不足而已。
血液病也是中医肾病的一种。
原始点疗法是如何解决白血病的
孕妇白血病
经原始点调理后,今天的恢复状态是必然,并不是因为原始点有多神奇,而恰恰只是因为原始点简单地遵循了自然之道。生命的存活是需要依靠热能的,没有了热能的身体,生命就不复存在,这是规律,是道!原始点不直接针对身体的症状处理,原始点是帮助身体增加热能,从而改善身体体质,为生命的存活创造最佳环境。当身体有足够的热能,身体内本有的自愈能力就会被激发、启动,从而由自愈能力去修复身体存在的各种症状。这才是从根、从因上解决问题,才是解决问题的根本方法、正道方法。
武陟原始点志愿者公益中心
活动时间:每周日上午:9:00——11:30下午3:00——6:00
地址:武陟县龙泉湖公园志愿者厅
官网http://cch-yuanshidian.com
邮箱:357523494@qq.com
武陟原始点学习微信群:武陟原始点学习群
武陟原始点学习群 QQ群号: 252101172
武陟原始点志愿者中心QQ群号: 325623839
原始点志愿者的精神:纯朴,利他,服务,奉献
——————————————————
爱好自己的心,在感恩中付出,自爱是报恩,付出是感恩!
常按上图关注公众号!
武陟原始点志愿者公益中心
活动时间:每周日上午:9:00——11:30下午3:00——6:00
地址:武陟县龙泉湖公园志愿者厅
官网http://cch-yuanshidian.com
邮箱:357523494@qq.com
武陟原始点学习微信群:武陟原始点学习群
武陟原始点学习群 QQ群号: 252101172
武陟原始点志愿者中心QQ群号: 325623839
原始点志愿者的精神:纯朴,利他,服务,奉献
——————————————————
爱好自己的心,在感恩中付出,自爱是报恩,付出是感恩!
常按上图关注公众号!
七不姜 生姜养生网-明德CSA生态姜园&明安农业












评论前必须登录!
立即登录 注册